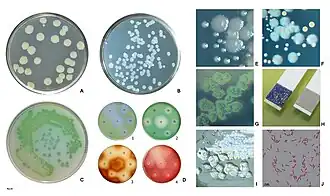
alternativní popis obrázku chybí
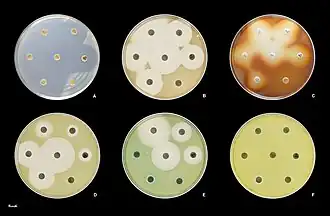
alternativní popis obrázku chybí

Pseudomonas aeruginosa
Produkce pigmentů kmeny P. aeruginosa. Žlutozelený pyoverdin, modrý pyocyanin, hnědy pyomelanin a červený pyorubrin. Bakterie jsou rezistentní na cetrimid (G), oxidázový test je pozitivní (H). Kultury často autolyzují v důsledku napadení bakteriofágy (I). Gram-negativní bakterie (J). | |
Citlivost kmenů P. aeruginosa stanovená diskovou difúzní metodou. Všechny kmeny jsou primárně rezistentní na co-trimoxazol (SXT). K terapii lze použít poměrně úzké spektrum tzv. antipseudomonádových antibiotik. | |
| Vědecká klasifikace | |
| Doména | bakterie (Bacteria) |
| Oddělení | Proteobacteria |
| Třída | Gamma Proteobacteria |
| Řád | Pseudomonadales |
| Čeleď | Pseudomonadaceae |
| Rod | Pseudomonas |
| Binomické jméno | |
| Pseudomonas aeruginosa Migula., 1900 | |
| Některá data mohou pocházet z datové položky. | |
Pseudomonas aeruginosa (syn. Bacterium pyocyaneum) je pohyblivá gramnegativní bakterie se slizovou vrstvou patřící do skupiny fluorescenčních pseudomonád. Jako potenciální patogen vyvolává řadu onemocnění, jako je zánět močových cest, středního ucha či hnisání popálenin.
Faktory virulence
Produkuje exotoxin A, který blokuje proteosyntézu. Alginát působí jako adhezivní faktor. Pyocyanin tvoří volné kyslíkové radikály. Pyoverdin je zodpovědný za vázání železa a zelenomodré zbarvení kolonií na krevním agaru. Dále produkuje proteázy a hemolyziny.
Patogenita
U pacientů s cystickou fibrózou způsobuje pneumonie. U diabetiků a intravenózních narkomanů je zodpovědná za osteomyelitidu. U pacientů, kteří mají dlouhodobě zavedený katétr může vyústit v pyelonefritidu. Je také obávaným agens infekce popálenin.
Terapie
Je značně rezistentní vůči antibiotikům a je pečlivě sledována v lékařství, hygienické a potravinářské mikrobiologii. Léčí se kombinací piperacilinu (jeden z ureidopenicilinů) v kombinaci s inhibitory beta-laktamáz. Některé kmeny jsou také citlivé na aminoglykosidy, karbapenemy (imipenem) a ciprofloxacin.
Externí odkazy
 Obrázky, zvuky či videa k tématu Pseudomonas aeruginosa na Wikimedia Commons
Obrázky, zvuky či videa k tématu Pseudomonas aeruginosa na Wikimedia Commons